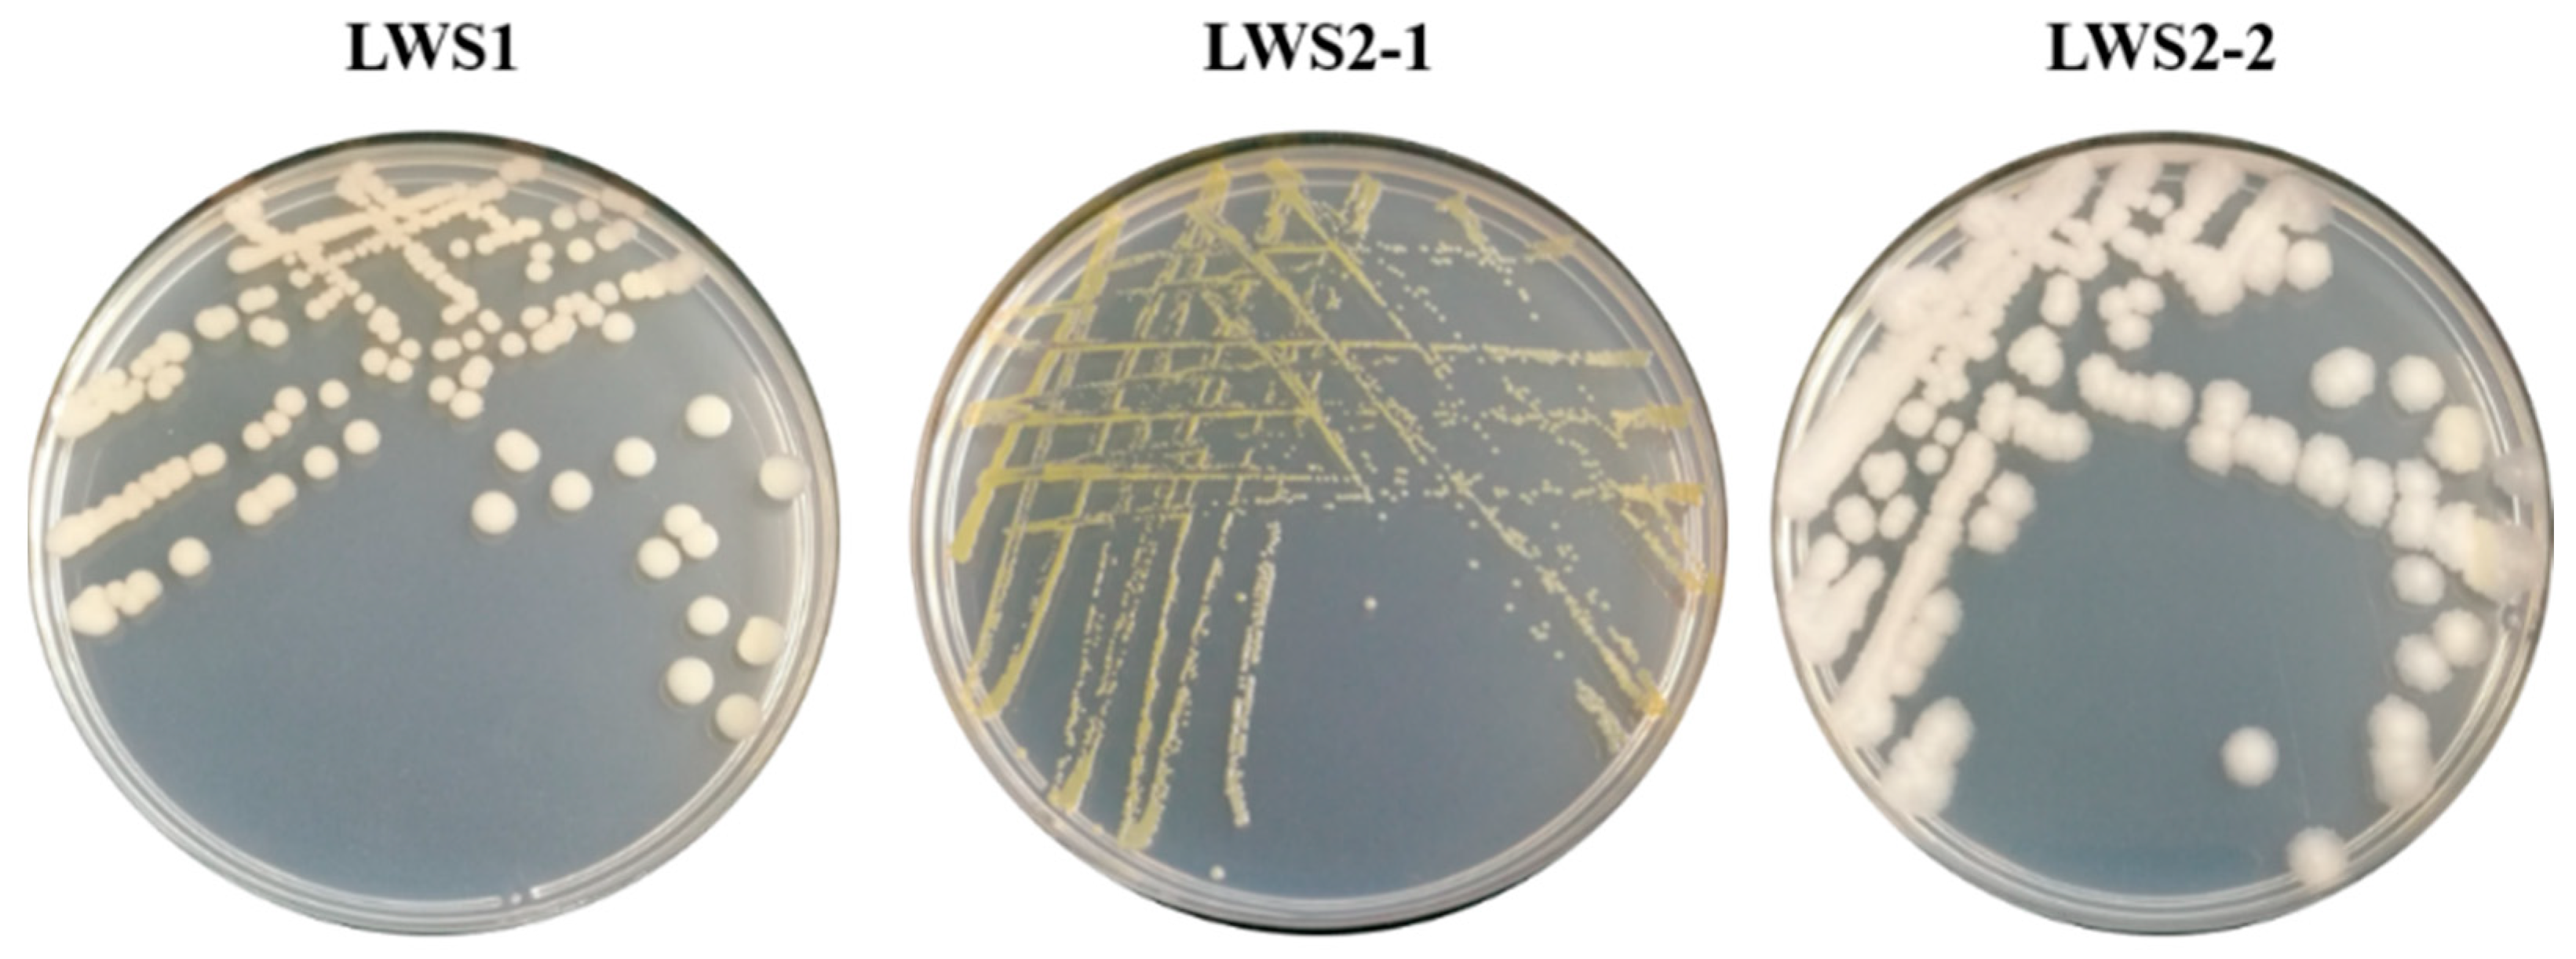
Agronomy 12 01301 g001 Agronomy 12 01301 g001

Priestia sp. LWS1 Is a Selenium-Resistant Plant Growth-Promoting Bacterium That Can Enhance Plant Growth and Selenium Accumulation in Oryza sativa L.
Abstract
1. Introduction
2. Materials and Methods
2.1. Microbial Screening and Identification
2.2. Analysis of Se Tolerance
2.3. Characterization of PGP Traits
2.4. Evaluation of the Effects of Strain LWS1 on Plant Growth and Se Accumulation in Rice
2.5. Statistical Analyses
3. Results and Discussion
3.1. Three Se-Tolerant Strains Were Isolated from Se Tailing Soil
3.2. Strain LWS1 Showed Great Se Tolerance
3.3. Strain LWS1 Exhibited Typical PGP Characteristics
3.4. Strain LWS1 Enhanced Plant Growth and Se Accumulation in Rice
4. Conclusions
Author Contributions
Funding
Institutional Review Board Statement
Informed Consent Statement
Data Availability Statement
Conflicts of Interest
References
- Hartikainen, H. Biogeochemistry of selenium and its impact on food chain quality and human health. J. Trace Elem. Med. Biol. 2005, 18, 309–318. [Google Scholar] [CrossRef] [PubMed]
- Lemly, A.D. Environmental implications of excessive selenium: A review. Biomed. Environ. Sci. 1997, 10, 415–435. [Google Scholar] [PubMed]
- Gupta, M.; Gupta, S. An overview of selenium uptake, metabolism, and toxicity in plants. Front. Plant Sci. 2017, 7, 2074. [Google Scholar] [CrossRef] [PubMed]
- Mistry, H.D.; Pipkin, F.B.; Redman, C.W.G.; Poston, L. Selenium in reproductive health. Am. J. Obstet. Gynecol. 2012, 206, 21–30. [Google Scholar] [CrossRef]
- Sarwar, N.; Akhtar, M.; Kamran, M.A.; Imran, M.; Riaz, M.A.; Kamran, K.; Hussain, S. Selenium biofortification in food crops: Key mechanisms and future perspectives. J. Food Compos. Anal. 2020, 93, 103615. [Google Scholar] [CrossRef]
- Ullah, H.; Liu, G.; Yousaf, B.; Ali, M.U.; Irshad, S.; Abbas, Q.; Ahmad, R. A comprehensive review on environmental transformation of selenium: Recent advances and research perspectives. Environ. Geochem. Health 2019, 41, 1003–1035. [Google Scholar] [CrossRef]
- Vleet, J.F.V.; Ferrans, V.J. Etiologic factors and pathologic alterations in selenium-vitamin E deficiency and excess in animals and humans. Biol. Trace Elem. Res. 1992, 33, 1–21. [Google Scholar] [CrossRef]
- Zhang, H.; Feng, X.; Chan, H.M.; Larssen, T. New insights into traditional health risk assessments of mercury exposure: Implications of selenium. Environ. Sci. Technol. 2014, 48, 1206–1212. [Google Scholar] [CrossRef]
- Kipp, A.P.; Strohm, D.; Brigelius-Flohé, R.; Schomburg, L.; Bechthold, A.; Leschik-Bonnet, E.; Heseker, H.; German Nutrition Society (DGE). Revised reference values for selenium intake. J. Trace Elem. Med. Bio. 2015, 32, 195–199. [Google Scholar] [CrossRef]
- Rayman, M.P. Selenium and human health. Lancet 2012, 379, 1256–1268. [Google Scholar] [CrossRef]
- Chen, Y.; Han, Y.-H.; Cao, Y.; Zhu, Y.-G.; Rathinasabapathi, B.; Ma, L.Q. Arsenic transport in rice and biological solutions to reduce arsenic risk from rice. Front. Plant Sci. 2017, 8, 268. [Google Scholar] [CrossRef] [PubMed]
- Williams, P.N.; Lombi, E.; Sun, G.-X.; Scheckel, K.; Zhu, Y.-G.; Feng, X.; Zhu, J.; Carey, A.-M.; Adomako, E.; Lawgali, Y.; et al. Selenium characterization in the global rice supply chain. Environ. Sci. Technol. 2009, 43, 6024–6030. [Google Scholar] [CrossRef] [PubMed]
- Zhang, L.; Shi, W.; Wang, X. Difference in selenite absorption between high-and low-selenium rice cultivars and its mechanism. Plant Soil 2006, 282, 183–193. [Google Scholar] [CrossRef]
- Zhu, Y.-G.; Pilon-Smits, E.A.H.; Zhao, F.-J.; Williams, P.N.; Meharg, A.A. Selenium in higher plants: Understanding mechanisms for biofortification and phytoremediation. Trends Plant Sci. 2009, 14, 436–442. [Google Scholar] [CrossRef] [PubMed]
- Schiavon, M.; Nardi, S.; Vecchia, F.d.; Ertani, A. Selenium biofortification in the 21st century: Status and challenges for healthy human nutrition. Plant Soil 2020, 453, 245–270. [Google Scholar] [CrossRef]
- Dai, Z.; Imtiaz, M.; Rizwan, M.; Yuan, Y.; Huang, H.; Tu, S. Dynamics of Selenium uptake, speciation, and antioxidant response in rice at different panicle initiation stages. Sci. Total Environ. 2019, 691, 827–834. [Google Scholar] [CrossRef]
- Versini, A.; Di Tullo, P.; Aubry, E.; Bueno, M.; Thiry, Y.; Pannier, F.; Castrec-Rouelle, M. Influence of Se concentrations and species in hydroponic cultures on Se uptake, translocation and assimilation in non-accumulator ryegrass. Plant Physiol. Bioch. 2016, 108, 372–380. [Google Scholar] [CrossRef]
- Eze, M.O.; Thiel, V.; Hose, G.C.; George, S.C.; Daniel, R. Enhancing rhizoremediation of petroleum hydrocarbons through bioaugmentation with a plant growth-promoting bacterial consortium. Chemosphere 2022, 289, 133143. [Google Scholar] [CrossRef]
- Goswami, D.; Thakker, J.N.; Dhandhukia, P.C. Portraying mechanics of plant growth promoting rhizobacteria (PGPR): A review. Cogent. Food Agric. 2016, 2, 1127500. [Google Scholar] [CrossRef]
- Rajkumar, M.; Ae, N.; Prasad, M.N.V.; Freitas, H. Potential of siderophore-producing bacteria for improving heavy metal phytoextraction. Trends Biotechnol. 2010, 28, 142–149. [Google Scholar] [CrossRef]
- Grandlic, C.J.; Mendez, M.O.; Chorover, J.; Machado, B.; Maier, R.M. Plant growth-promoting bacteria for phytostabilization of mine tailings. Environ. Sci. Technol. 2008, 42, 2079–2084. [Google Scholar] [CrossRef] [PubMed]
- Khan, S.; Afzal, M.; Iqbal, S.; Khan, Q.M. Plant–bacteria partnerships for the remediation of hydrocarbon contaminated soils. Chemosphere 2013, 90, 1317–1332. [Google Scholar] [CrossRef] [PubMed]
- Jiang, C.-y.; Sheng, X.-f.; Qian, M.; Wang, Q.-y. Isolation and characterization of a heavy metal-resistant Burkholderia sp. from heavy metal-contaminated paddy field soil and its potential in promoting plant growth and heavy metal accumulation in metal-polluted soil. Chemosphere 2008, 72, 157–164. [Google Scholar] [CrossRef] [PubMed]
- Rajkumar, M.; Ma, Y.; Freitas, H. Improvement of Ni phytostabilization by inoculation of Ni resistant Bacillus megaterium SR28C. J. Environ. Manag. 2013, 128, 973–980. [Google Scholar] [CrossRef] [PubMed]
- Yang, D.; Hu, C.; Wang, X.; Shi, G.; Li, Y.; Fei, Y.; Song, Y.; Zhao, X. Microbes: A potential tool for selenium biofortification. Metallomics 2021, 13, mfab054. [Google Scholar] [CrossRef]
- Ye, Y.; Qu, J.; Pu, Y.; Rao, S.; Xu, F.; Wu, C. Selenium biofortification of crop food by beneficial microorganisms. J. Fungi 2020, 6, 59. [Google Scholar] [CrossRef]
- Yasin, M.; El-Mehdawi, A.F.; Anwar, A.; Pilon-Smits, E.A.H.; Faisal, M. Microbial-enhanced selenium and iron biofortification of wheat (Triticum aestivum L.)-Applications in phytoremediation and biofortification. Int. J. Phytoremediat. 2015, 17, 341–347. [Google Scholar] [CrossRef]
- Durán, P.; Acuña, J.J.; Armada, E.; López-Castillo, O.M.; Cornejo, P.; Mora, M.L.; Azcón, R. Inoculation with selenobacteria and arbuscular mycorrhizal fungi to enhance selenium content in lettuce plants and improve tolerance against drought stress. J. Soil Sci. Plant Nutr. 2016, 16, 201–225. [Google Scholar] [CrossRef][Green Version]
- White, P.J. Selenium metabolism in plants. BBA Gen. Subj. 2018, 1862, 2333–2342. [Google Scholar] [CrossRef]
- Han, Y.-H.; Yin, D.-X.; Jia, M.-R.; Wang, S.-S.; Chen, Y.; Rathinasabapathi, B.; Chen, D.-L.; Ma, L.Q. Arsenic-resistance mechanisms in bacterium Leclercia adecarboxylata strain As3-1: Biochemical and genomic analyses. Sci. Total Environ. 2019, 690, 1178–1189. [Google Scholar] [CrossRef]
- Wang, S.-S.; Ye, S.-L.; Han, Y.-H.; Shi, X.-X.; Chen, D.-L.; Li, M. Biosorption and bioaccumulation of chromate from aqueous solution by a newly isolated Bacillus mycoides strain 200AsB1. RSC Adv. 2016, 6, 101153–101161. [Google Scholar] [CrossRef]
- Jouanneau, Y.; Meyer, C.; Duraffourg, N. Dihydroxylation of four- and five-ring aromatic hydrocarbons by the naphthalene dioxygenase from Sphingomonas CHY-1. Appl. Microbiol. Biotechnol. 2016, 100, 1253–1263. [Google Scholar] [CrossRef] [PubMed]
- Xu, J.-Y.; Han, Y.-H.; Chen, Y.; Zhu, L.-J.; Ma, L.Q. Arsenic transformation and plant growth promotion characteristics of As-resistant endophytic bacteria from As-hyperaccumulator Pteris vittata. Chemosphere 2016, 144, 1233–1240. [Google Scholar] [CrossRef] [PubMed]
- Gordon, S.A.; Weber, R.P. Colorimetric estimation of indoleacetic acid. Plant Physiol. 1951, 26, 192–195. [Google Scholar] [CrossRef]
- Schwyn, B.; Neilands, J. Universal chemical assay for the detection and determination of siderophores. Anal. Biochem. 1987, 160, 47–56. [Google Scholar] [CrossRef]
- Nautiyal, C.S. An efficient microbiological growth medium for screening phosphate solubilizing microorganisms. FEMS Microbiol. Lett. 1999, 170, 265–270. [Google Scholar] [CrossRef]
- Watanabe, F.S.; Olsen, S.R. Test of an ascorbic acid method for determining phosphorus in water and NaHCO3 extracts from soil. Soil Sci. Soc. Am. J. 1965, 29, 677–678. [Google Scholar] [CrossRef]
- Eze, M.O.; George, S.C.; Hose, G.C. Dose-response analysis of diesel fuel phytotoxicity on selected plant species. Chemosphere 2021, 263, 128382. [Google Scholar] [CrossRef]
- Eze, M.O.; Hose, G.C.; George, S.C. Assessing the effect of diesel fuel on the seed viability and germination of Medicago sativa using the event-time model. Plants 2020, 9, 1062. [Google Scholar] [CrossRef]
- Liang, S.; Guan, D.-X.; Ren, J.-H.; Zhang, M.; Luo, J.; Ma, L.Q. Effect of aging on arsenic and lead fractionation and availability in soils: Coupling sequential extractions with diffusive gradients in thin-films technique. J. Hazard. Mater. 2014, 273, 272–279. [Google Scholar] [CrossRef]
- Xu, J.-Y.; Li, H.-B.; Liang, S.; Luo, J.; Ma, L.Q. Arsenic enhanced plant growth and altered rhizosphere characteristics of hyperaccumulator Pteris vittata. Environ. Pollut. 2014, 194, 105–111. [Google Scholar] [CrossRef] [PubMed]
- Aleixo, P.C.; Nóbrega, J.A. Direct determination of iron and selenium in bovine milk by graphite furnace atomic absorption spectrometry. Food Chem. 2003, 83, 457–462. [Google Scholar] [CrossRef]
- Bao, M.-T.; Wang, L.-N.; Sun, P.-Y.; Cao, L.-X.; Zou, J.; Li, Y.-M. Biodegradation of crude oil using an efficient microbial consortium in a simulated marine environment. Mar. Pollut. Bull. 2012, 64, 1177–1185. [Google Scholar] [CrossRef] [PubMed]
- Zhou, J.; Ma, Q.; Yi, H.; Wang, L.; Song, H.; Yuan, Y.-J. Metabolome profiling reveals metabolic cooperation between Bacillus megaterium and Ketogulonicigenium vulgare during induced swarm motility. Appl. Environ. Microbiol. 2011, 77, 7023–7030. [Google Scholar] [CrossRef] [PubMed]
- Hossain, T.J.; Das, M.; Ali, F.; Chowdhury, S.I.; Zedny, S.A. Substrate preferences, phylogenetic and biochemical properties of proteolytic bacteria present in the digestive tract of Nile tilapia (Oreochromis niloticus). AIMS Microbiol. 2021, 7, 528–545. [Google Scholar] [CrossRef] [PubMed]
- Masscheleyn, P.H.; Patrick, W.H., Jr. Biogeochemical processes affecting selenium cycling in wetlands. Environ. Toxicol. Chem. 1993, 12, 2235–2243. [Google Scholar] [CrossRef]
- Mishra, R.R.; Prajapati, u.; Das, J.; Dangar, T.K.; Das, N.; Thatoi, H. Reduction of selenite to red elemental selenium by moderately halotolerant Bacillus megaterium strains isolated from Bhitarkanika mangrove soil and characterization of reduced product. Chemosphere 2011, 84, 1231–1237. [Google Scholar] [CrossRef]
- Hashem, A.H.; Abdelaziz, A.M.; Askar, A.A.; Fouda, H.M.; Khalil, A.M.A.; Abd-Elsalam, K.A.; Khaleil, M.M. Bacillus megaterium-mediated synthesis of selenium nanoparticles and their antifungal activity against Rhizoctonia solani in faba bean plants. J. Fungi 2021, 7, 195. [Google Scholar] [CrossRef]
- Ramamurthy, C.; Sampath, K.S.; Arunkumar, P.; Kumar, M.S.; Sujatha, V.; Premkumar, K.; Thirunavukkarasu, C. Green synthesis and characterization of selenium nanoparticles and its augmented cytotoxicity with doxorubicin on cancer cells. Bioproc. Biosyst. Eng. 2013, 36, 1131–1139. [Google Scholar] [CrossRef]
- Sarathchandra, S.U.; Watkinson, J.H. Oxidation of elemental selenium to selenite by Bacillus megaterium. Science 1981, 211, 600–601. [Google Scholar] [CrossRef]
- Ghosh, A.; Mohod, A.M.; Paknikar, K.M.; Jain, R.K. Isolation and characterization of selenite- and selenate-tolerant microorganisms from selenium-contaminated sites. World J. Microbiol. Biotechnol. 2008, 24, 1607–1611. [Google Scholar] [CrossRef]
- Durán, P.; Acuña, J.J.; Jorquera, M.A.; Azcón, R.; Paredes, C.; Rengel, Z.; de la Luz Mora, M. Endophytic bacteria from selenium-supplemented wheat plants could be useful for plant-growth promotion, biofortification and Gaeumannomyces graminis biocontrol in wheat production. Biol. Fert. Soils 2014, 50, 983–990. [Google Scholar] [CrossRef]
- Kaur, T.; Vashisht, A.; Prakash, N.T.; Reddy, M.S. Role of selenium-tolerant fungi on plant growth promotion and selenium accumulation of maize plants grown in seleniferous soils. Water Air Soil Pollut. 2022, 233, 17. [Google Scholar] [CrossRef]
- Li, Q.; Zhou, S.; Liu, N. Diversity of endophytic bacteria in Cardamine hupingshanensis and potential of culturable selenium-resistant endophytes to enhance seed germination under selenate stress. Curr. Microbiol. 2021, 78, 2091–2103. [Google Scholar] [CrossRef] [PubMed]
- Huddedar, S.B.; Shete, A.M.; Tilekar, J.N.; Gore, S.D.; Dhavale, D.D.; Chopade, B.A. Isolation, characterization, and plasmid pUPI126-mediated indole-3-acetic acid production in Acinetobacter strains from rhizosphere of wheat. Appl. Biochem. Biotechnol. 2002, 102, 21–39. [Google Scholar] [CrossRef]
- Ghosh, P.; Rathinasabapathi, B.; Teplitski, M.; Ma, L.Q. Bacterial ability in AsIII oxidation and AsV reduction: Relation to arsenic tolerance, P uptake, and siderophore production. Chemosphere 2015, 138, 995–1000. [Google Scholar] [CrossRef]
- Hu, X.; Boyer, G.L. Siderophore-mediated Al uptake by Bacillus megaterium ATCC 19213. Appl. Environ. Microbiol. 1996, 62, 4044–4048. [Google Scholar] [CrossRef]
- Njokua, K.L.; Akinyede, O.R.; Obidi, O.F. Microbial remediation of heavy metals contaminated media by Bacillus megaterium and Rhizopus stolonifer. Sci. Afr. 2020, 10, e00545. [Google Scholar] [CrossRef]
- Zou, C.; Li, Z.; Yu, D. Bacillus megaterium strain XTBG34 promotes plant growth by producing 2-pentylfuran. J. Microbiol. 2010, 48, 460–466. [Google Scholar] [CrossRef]
- Chakraborty, U.; Chakraborty, B.; Basnet, M. Plant growth promotion and induction of resistance in Camellia sinensis by Bacillus megaterium. J. Basic Microbiol. 2006, 46, 186–195. [Google Scholar] [CrossRef]
- Wu, J.; Kamal, N.; Hao, H.; Qian, C.; Liu, Z.; Shao, Y.; Zhong, X.; Xu, B. Endophytic Bacillus megaterium BM18-2 mutated for cadmium accumulation and improving plant growth in Hybrid Pennisetum. Biotechnol. Rep. 2019, 24, e00374. [Google Scholar] [CrossRef] [PubMed]
- Vary, P.S.; Biedendieck, R.; Fuerch, T.; Meinhardt, F.; Rohde, M.; Deckwer, W.-D.; Jahn, D. Bacillus megaterium—from simple soil bacterium to industrial protein production host. Appl. Microbiol. Biotechnol. 2007, 76, 957–967. [Google Scholar] [CrossRef] [PubMed]

| Microbes | Strain | Sources | Se Tolerance (MIC, mM) | IAA-Producing Ability (mg·L−1) | Siderophore-Producing Ability (λ/λ0) 1 | Phosphate-Solubilizing Ability (mg·L−1) | Promoted Plants | Reference |
|---|---|---|---|---|---|---|---|---|
| Acinetobacter sp. | E6.2 | Wheat stem | 60 | 37.9 | – 2 | – | Wheat | Durán et al. [52] |
| Priestia megaterium | CHP08 | Cardamine hupingshanensis | 50 (SeIV); 200 (SeVI) | 11.5 ± 3.5 | – | 58.8 ± 24.1 | Brassica chinensis | Li et al. [54] |
| Bacillus pichinotyi | YAM2 | Sediment | – | 12 | n.m. 3 | – | Wheat (Triticum aestivum L.) | Yasin et al. [27] |
| Bacillus sp. | E6.1 | Wheat stem | 120 | 39.9 | – | – | Wheat | Durán et al. [52] |
| Bacillus sp. | CHP07 | Cardamine hupingshanensis | 80 (SeIV); 450 (SeVI) | 41.0 ± 11.9 | – | – | Brassica chinensis | Li et al. [47] |
| Fusarium equiseti | SeF5 | Soil | >80 | 64.28 ± 1.2 | 0.155 | n.m.c | maize | Kaur et al. [53] |
| Klebsiella sp. | E2 | Wheat stem | 180 | 94.1 | + | + | Wheat | Durán et al. [52] |
| Herbaspirillum camelliae | WT00C | Tea | n.m. | 18.7 | + | n.m. | Tea | Cheng et al. [43] |
| Paenibacillus favisporus | CHP14 | Cardamine hupingshanensis | 70 (SeIV); 400 (SeVI) | 28.2 ± 4.5 | + | 27.6 ± 11.5 | Brassica chinensis | Li et al. [47] |
| Pseudopestalotiopsis theae | SeF12 | Soil | >80 | 52.89 ± 1.02 | 0.317 | n.m.c | maize | Kaur et al. [53] |
| Priestia sp. | LWS1 | Se tailing | >90 | 24.3 ± 1.37 | 0.23 ± 0.04 | 87.5 ± 0.21 | Rice (Oryza sativa L.) | In this study |
Publisher’s Note: MDPI stays neutral with regard to jurisdictional claims in published maps and institutional affiliations. |
© 2022 by the authors. Licensee MDPI, Basel, Switzerland. This article is an open access article distributed under the terms and conditions of the Creative Commons Attribution (CC BY) license (https://creativecommons.org/licenses/by/4.0/).
Share and Cite
Lin, X.-R.; Chen, H.-B.; Li, Y.-X.; Zhou, Z.-H.; Li, J.-B.; Wang, Y.-Q.; Zhang, H.; Zhang, Y.; Han, Y.-H.; Wang, S.-S. Priestia sp. LWS1 Is a Selenium-Resistant Plant Growth-Promoting Bacterium That Can Enhance Plant Growth and Selenium Accumulation in Oryza sativa L. Agronomy 2022, 12, 1301. https://doi.org/10.3390/agronomy12061301
Lin X-R, Chen H-B, Li Y-X, Zhou Z-H, Li J-B, Wang Y-Q, Zhang H, Zhang Y, Han Y-H, Wang S-S. Priestia sp. LWS1 Is a Selenium-Resistant Plant Growth-Promoting Bacterium That Can Enhance Plant Growth and Selenium Accumulation in Oryza sativa L. Agronomy. 2022; 12(6):1301. https://doi.org/10.3390/agronomy12061301
Chicago/Turabian StyleLin, Xiao-Rui, Han-Bing Chen, Yi-Xi Li, Zhi-Hua Zhou, Jia-Bing Li, Yao-Qiang Wang, Hong Zhang, Yong Zhang, Yong-He Han, and Shan-Shan Wang. 2022. "Priestia sp. LWS1 Is a Selenium-Resistant Plant Growth-Promoting Bacterium That Can Enhance Plant Growth and Selenium Accumulation in Oryza sativa L." Agronomy 12, no. 6: 1301. https://doi.org/10.3390/agronomy12061301
APA StyleLin, X.-R., Chen, H.-B., Li, Y.-X., Zhou, Z.-H., Li, J.-B., Wang, Y.-Q., Zhang, H., Zhang, Y., Han, Y.-H., & Wang, S.-S. (2022). Priestia sp. LWS1 Is a Selenium-Resistant Plant Growth-Promoting Bacterium That Can Enhance Plant Growth and Selenium Accumulation in Oryza sativa L. Agronomy, 12(6), 1301. https://doi.org/10.3390/agronomy12061301

